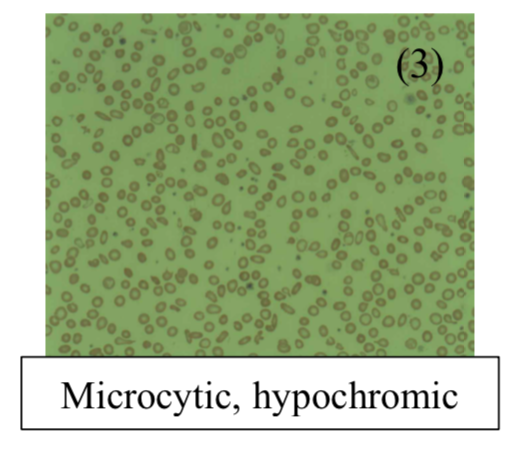
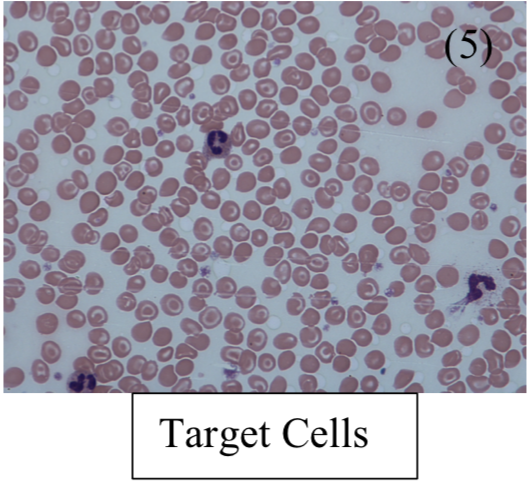

Back to: Haematology
Microcytic Anaemia
A problem in haemoglobin results in the improper folding in RBC leading to a reduced cell mass.
– Due to the structure of haemoglobin, it is caused by deficits in haem group or Hb chains themselves.
Iron Deficiency Anaemia (IDA)
This is a microcytic anaemia which occurs due to decreased levels of iron, most common worldwide.
Causes:
– Blood loss –> GI bleeding or menstruation (seen in 14% of women)
– Poor diet –> seen in babies or children
– Malabsorption –> coeliac disease, due to inflammation of the small bowel
Symptoms:
– General signs of anaemia
– Koilonychia (spoon-shaped nails)
– Pica (disorder where you eat random stuff e.g. dirt)
– Angular stomatitis
– Atrophic glossitis (beefy red tongue)
– Plummer-Vinson Syndrome = Iron deficiency anaemia + oesophageal web + atrophic glossitis

Tests:
– Blood film shows microcytic, hypochromic RBCs – Get pencil poikilocytosis (abnormal shape) + target cells
– Iron studies –> low ferritin, high TIBC, low serum iron, low % saturation
– Blood test –> shows raised free erythrocyte protoporphyrin (FEP). This makes up the other component of haem with iron, so more is unbound in low Fe2
Management:
– Must find out the underlying cause
– Check coeliac serology to find out about possible malabsorption disorder
– If this is negative, refer for urgent gastroscopy and colonoscopy
– If all ok, treat with iron supplements, (ferrous sulphate)
Anaemia of chronic disease
This is anaemia associated with chronic inflammation (autoimmune conditions) or cancer
– It is the 2nd most common anaemia worldwide and most common type of anaemia in hospital patients
– Chronic disease results in production of acute phase reactants from the liver such as hepcidin
– This limits iron transfer to RBC precursors and stops EPO release from the kidney
– The aim is to prevent bacteria from accessing iron, which is necessary for their survival
Tests:
– Iron studies –> Raised ferritin + low TIBC + low serum iron + low saturation
– Blood test –> shows raised free erythrocyte protoporphyrin (FEP)
Management:
– Address underlying cause
– Blood transfusions if Hb drops too low
– Erythropoietin is given in renal disease
Sideroblastic anaemia
This is a microcytic anaemia due to defective protoporphyrin synthesis.
– Usually protoporphyrin is made in a series of enzyme-controlled reactions
– Main enzyme = ALAS
– Fe2+ is then transferred to RBC precursors and enters mitochondria to form haem.
– But if the protoporphyrin is deficient, Fe2+ remains trapped in mitochondria, and accumulates to form a ring around nucleus of RBC precursors, hence they are called ringed sideroblasts.
– Characterized by ineffective RBC production, with increased Fe2+ deposition in liver/heart
Causes:
– Congenital defect in ALAS enzyme (involved in protoporphyrin synthesis)
– Acquired –> Lead poisoning or Vitamin B6 deficiency (cofactor for ALAS)
Tests:
– Iron studies –> Raised ferritin + low TIBC + high serum iron + high saturation
– Bone marrow biopsy – shows disease defining sideroblasts

Management:
– If lead poisoning, give dimercaprol + give pyridoxine (Vitamin B6) and transfusions if severe anaemia
Thalassemia
This is anaemia due to decreased synthesis of the globin chains of haemoglobin. They are common in the Mediterranean and Africa and divided into alpha/beta-thalassemia based on the chain affected.
– Normal form of haemoglobin is HBA(a2B2) but also normal variant HbA2 (a2d2) and fetal HbF (a2g2)
– It leads to reduced RBC production –> this gives RBCs which are microcytic + hypochromic
– Also causes excess of the unaffected chain which precipitates as inclusions damaging membranes
Tests:
– Blood test and film
– Hb electrophoresis –> Definitive diagnostic test
Alpha-Thalassemia
The a-chain are encoded by two duplicated genes on chromosome 16, each which contribute 25%.
1 gene deleted (-a/aa):
Asymptomatic [ Blood is hypochromic + microcytic, but the Hb level is usually normal]
2 genes deleted (-a/-a):
a-thalassemia trait [ Blood is hypochromic + microcytic, but the Hb level is usually normal]
3 genes deleted (–/-a):
This leads to HbH disease. The lack of a chains means there is formation of b4 tetramers. However, this is less serious than b-thalassemia as they are more soluble than a-chains
4 genes deleted (–/–):
This is Bart’s disease, leads to death in utero
Symptoms:
– Moderate anemia –> tiredness, lethargy, dyspnea etc.
– Extramedullary hematopoiesis –> Splenomegaly
– Some Haemolysis –> Jaundice + gallstones
Diagnosis:
– Blood film – shows hypochromic + target cells
– Hb Electrophoresis
– Iron studies also done to exclude iron deficiency anaemia
Management:
– Constant infusions and possible splenectomy
– Cure is complete bone marrow transplant
Beta-Thalassemia
Two ß-genes are present on Chr 11 –mutation result in loss of chain (ß0) or diminished synthesis (ß+)
ß-thalassemia trait (ß/ß+):
This is an autosomal recessive disease which is asymptomatic
– Gives mild microcytic hypochromic anaemia – but the microcytosis is characteristically much disproportionate to the anaemia (i.e. MCV much lower for the Hb level)
– Hb electrophoresis shows ↓HbA (a2ß2) with ↑HbA2 (a2d2) >3.5% and increased HbF (a2γ2)
ß-major(ß0/ß0):
This is a severe form due to mutations giving complete absence of b-globin genes
Symptoms:
– Presents in first year with failure to thrive and a microcytic anaemia
– a-tetramers aggregate damaging RBCs –> ineffective erythropoiesis + haemolysis
– Causes extra-medullary hematopoiesis to compensate leading to enlargement of the skull (crewcut appearance) and facial bone (chipmunk facies)
– Splenomegaly + hepatomegaly
Tests:
– Blood smear shows microcytic hypochromic cells.
– Hb electrophoresis shows HbA absent with raised HbA2 (>3.5%) and HbF
Management:
– Lifelong transfusions needed –> leads to iron overload (haemochromatosis)
– Iron overload managed with subcutaneous infusions of deferrioxamine
– Splenectomy if the hypersplenism remains
– Cure is complete bone marrow transplant
Condition | Ferritin | TIBC | Serum Iron | %saturation |
Iron Deficiency Anaemia | Low | High | Low | Low |
Anaemia of Chronic Disease | High | Low | Low | Low |
Sideroblastic Anaemia | High | Normal/Low | Normal/HIgh | High |
Pregnancy + Contraceptives | – | High | – | Low |
Sources
Image 1: C Heitz, CC BY 2.0 <https://creativecommons.org/licenses/by/2.0>, via Wikimedia Commons
Image 2: Matthew Ferguson 57, CC BY-SA 3.0 <https://creativecommons.org/licenses/by-sa/3.0>, via Wikimedia Commons
Image 3: Prof. Osaro Erhabor, CC0, via Wikimedia Commons
Image 4: Paulo Henrique Orlandi Mourao, CC BY-SA 3.0 <https://creativecommons.org/licenses/by-sa/3.0>, via Wikimedia Commons
Image 5: Dr Graham Beards, CC BY-SA 3.0 <https://creativecommons.org/licenses/by-sa/3.0>, via Wikimedia Commons


